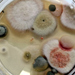
image.title
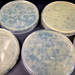
image.title
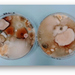
image.title
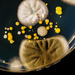
image.title

-
Pilze
© Hochschule Offenburg
Pilze, durch Auslegen von speziellen Agarplatten an der frischen Luft quasi "eingesammelt wurden -
Bakterien wurden von spreziellen Viren infiziert und zerstört
© Hochschule Offenburg
Was hier aussieht wie die Mondoberfläche ist das Muster, welches entsteht, wenn Bakterien von speziellen Viren infiziert und dadurch zerstört werden. Diese Viren nennen sich Phagen und sind nur infektiös für Bakterien - nicht für Menschen. Das ist praktisch, denn dies ermöglicht eine Verwendung von Phagen als alternative Therapie gegen antibiotikaresistente Bakterien. Wie man Phagen aus Abwasser isoliert lernen unsere StudentInnen der Biotechnologie im Mikrobiologie-Praktikum. -
Mikrobiologie Labor Proben
© Hochschule Offenburg
Mikrobiologie Laborproben -
Petrischale mit Bakterien
© science photo